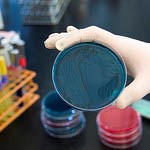

Nghiên cứu thuốc mới cho điều trị luôn là một nhiệm vụ hàng đầu của ngành dược và ngành y mỗi nước. Việc nghiên cứu thành công thuốc mới mang lại hy vọng sống cho người bệnh, đặc biệt các bệnh ác tính.
1. Nghiên cứu thuốc mới là gì?
Nghiên cứu, phát triển thuốc mới là tìm ra giải pháp điều trị hiệu quả, an toàn và hợp lý. Việc mỗi quốc gia tự nghiên cứu, phát triển thuốc mới sẽ góp phần bảo đảm an ninh y tế quốc gia và hội nhập vào chuỗi cung ứng toàn cầu.
Mục tiêu của việc nghiên cứu và phát triển thuốc mới nhằm: đảm bảo cung ứng đủ thuốc chất lượng cho nhu cầu phòng bệnh, chữa bệnh; phát triển năng lực nghiên cứu và sản xuất thuốc biệt dược gốc, vắc xin, sinh phẩm; nâng cao giá trị xuất khẩu và xây dựng nền công nghiệp dược hiện đại, ngang tầm quốc tế.
2. Sự phối hợp và cơ sở trong nghiên cứu, phát triển thuốc mới
2.1. Sự phối hợp để nghiên cứu và phát triển thuốc mới
Sứ mệnh của các công ty nghiên cứu dược phẩm là tìm ra những loại thuốc mới để điều trị bệnh và vắc xin mới để phòng bệnh một cách an toàn và hiệu quả hơn. Các nhà khoa học làm việc theo từng lĩnh vực phối hợp với nhau để nghiên cứu và phát triển các loại thuốc mới dựa trên hiểu biết về nguyên nhân gây bệnh ở mức độ cơ quan, tế bào, protein và gen. Từ những hiểu biết đó để xác định “đích tác dụng” của thuốc, nơi mà các phân tử thuốc mới có thể tấn công, biến đổi, phong toả, tiêu diệt các tác nhân gây bệnh.
Để đạt được mục này, các nhà nghiên cứu cần:
– Đánh giá các đích tác dụng của thuốc;
– Tìm kiếm được đúng các phân tử thuốc (các thuốc có khả năng) liên kết với các đích đã chọn;
– Kiểm tra hợp chất mới trong phòng thí nghiệm và trên lâm sàng về độ an toàn và hiệu quả của thuốc;
– Đạt được sự chấp thuận của cơ quan có thẩm quyền và đưa thuốc mới tới tay các bác sĩ để sử dụng cho việc điều trị bệnh.
Tuỳ thuộc vào trình độ phát triển y học và điều kiện kinh tế của mỗi nước, thời gian để hoàn thiện tất cả bước nghiên cứu và phát triển thuốc mới này sẽ mất khoảng từ 10-15 năm.
2.2. Cơ sở để nghiên cứu và phát triển thuốc mới
Để có thể khống chế và loại trừ bệnh tật, việc đầu tiên mà các nhà khoa học cần tìm hiểu chính là cơ chế hoạt động của bệnh trong cơ thể người ở mức độ phân tử. Các tiến bộ gần đây của khoa học nói chung và y sinh học nói riêng trong các lĩnh vực gen, protein và sức mạnh của máy tính, internet, trí tuệ nhân tạo (AI) đã giúp các nhà khoa học hiểu biết sâu hơn, cụ thể hơn về bệnh. Từ những hiểu biết đó đã giúp các nhà khoa học có những cách tiếp cận phù hợp trong nghiên cứu về các loại thuốc mới, vắc xin mới và phương pháp mới để điều trị, loại trừ và thanh toán bệnh, đặc biệt các bệnh ác tính, như: điều trị nhắm đích, gen điều trị, miễn dịch điều trị, …
Công cuộc tìm kiếm và phát triển thuốc an toàn và hiệu quả cho điều trị sẽ có nhiều hi vọng hơn khi những kiến thức và hiểu biết về bệnh học tăng lên. Khi xuất hiện các tác nhân gây bệnh mới, các lại vi rút và vi khuẩn mới thì việc nghiên cứu và phát triển các loại thuốc mới ngày càng trở nên thách thức hơn. Trên thế giới, Mỹ là nước đi đầu trong hoạt động nghiên cứu và phát triển thuốc mới. Quy trình nghiên cứu thuốc mới của Mỹ được cho là hoàn thiện hơn cả so với các nước và khu vực khác. Bài viết này cơ bản dựa trên quy trình nghiên cứu thuốc mới của Mỹ.
Sẽ cần khoảng thời gian từ 10-15 năm để phát triển một loại thuốc mới từ giai đoạn phát hiện cho tới khi đưa vào điều trị cho người bệnh. Chi phí trung bình cho việc nghiên cứu và phát triển thành công một thuốc mới vào khoảng 800 triệu USD đến 1 tỷ USD. Con số này sẽ bao gồm cả chi phí cho hàng nghìn những thất bại. Cứ mỗi 5.000 – 10.000 hợp chất tham gia vào quá trình nghiên cứu và phát triển thì cuối cùng cũng chỉ có khoảng 1-2 chất có hiệu quả và được chấp thuận tiếp tục nghiên cứu.
Những con số về thời gian và kinh phí để phát triển thuốc mới thực sự thách thức các nhà khoa học. Tuy vậy, việc nghiên cứu và phát triển thuốc mới không thể không được tiến hành. Việc tìm ra một thuốc mới để điều trị cho người bệnh đòi hỏi những nỗ lực lớn và kéo dài.
Thành công của việc nghiên cứu thuốc mới đòi hỏi những nguồn lực rộng lớn, những ý tưởng khoa học tốt nhất, năng lực quản lý dự án chuyên nghiệp và bài bản. Ngoài ra, việc nghiên cứu cũng cần tới cả sự kiên trì, và đôi khi là cả may mắn. Mặc dù vậy, quá trình tìm kiếm thuốc mới sẽ luôn mang lại hi vọng và sự cứu giúp tới hàng triệu bệnh nhân.
3. Các giai đoạn của nghiên cứu và phát triển thuốc mới
Để bảo đảm thuốc mới đáp ứng được các yêu cầu an toàn, đặc hiệu và hiệu quả, việc nghiên cứu và phát triển thuốc mới (quy trình phát triển thuốc mới) thường phải trải qua các bước như sau:
– Bước 1: Khám phá và phát triển;
– Bước 2: Nghiên cứu tiền lâm sàng;
– Bước 3: Nghiên cứu lâm sàng;
– Bước 4: Đánh giá của cơ quan có thẩm quyền về thuốc mới;
– Bước 5: Giám sát an toàn sau khi thuốc mới đưa ra thị trường của cơ quan có thẩm quyền.
Trong mỗi bước trên lại bao gồm nhiều hoạt động, giai đoạn hoặc thủ tục khác nhau. Do kết quả của nghiên cứu là các sản phẩm tác động lên sức khoẻ con người nên ngoài giá trị kinh tế thì trên hết phải là các tiêu chuẩn đạo đức khắt khe và quy trình nghiên cứu chặt chẽ nhất. Do vậy, để thực hiện được các bước tiếp theo thì các bước trước đó phải được thẩm định và chấp thuận. Đặc biệt là đến bước 3: Nghiên cứu lâm sàng.
3.1. Khám phá và phát triển
a. Khám phá
Thông thường, các nhà nghiên cứu khám phá ra các loại thuốc mới thông qua:
– Những hiểu biết mới về diễn biến quá trình bệnh tật (cơ chế bệnh sinh) cho phép các nhà nghiên cứu thiết kế sản phẩm thuốc để ngăn chặn hoặc đảo ngược tác động của bệnh.
– Nhiều thử nghiệm về hợp chất phân tử để tìm ra tác dụng có lợi có thể có đối với nhiều loại bệnh.
– Các loại thuốc điều trị hiện tại có tác dụng phụ không lường trước được.
– Các công nghệ mới, chẳng hạn như công nghệ cung cấp những cách thức mới để đưa các phân tử thuốc đến những vị trí cụ thể trong cơ thể hoặc để tác động đến vật liệu di truyền.
Ở giai đoạn bắt đầu này của quá trình nghiên cứu thuốc mới, hàng ngàn hợp chất có thể được xem xét là những hợp chất tiềm năng cho việc phát triển thành thuốc mới cho điều trị bệnh. Tuy nhiên, sau nhiều thử nghiệm ban đầu, chỉ một số ít hợp chất đáp ứng được mong muốn và chúng cần tiếp tục được nghiên cứu thêm.
b. Phát triển
Khi các nhà nghiên cứu xác định được một vài hợp chất có triển vọng để phát triển, họ sẽ tiến hành các thí nghiệm để thu thập thông tin về:
- Cách thức hấp thụ, phân phối, chuyển hóa và bài tiết;
- Lợi ích tiềm năng và cơ chế hoạt động của nó;
- Liều lượng tốt nhất;
- Cách tốt nhất để đưa thuốc vào cơ thể (như uống hoặc tiêm);
- Tác dụng phụ hoặc sự kiện bất lợi thường được gọi là độc tính;
- Cách nó ảnh hưởng đến các nhóm người khác nhau (chẳng hạn như theo giới tính, độ tuổi, chủng tộc hoặc dân tộc) một cách khác nhau;
- Tương tác của nó với các loại thuốc và phương pháp điều trị khác;
- Hiệu quả của nó khi so sánh với các loại thuốc tương tự.
3.2. Nghiên cứu tiền lâm sàng
Trước khi thử nghiệm một loại thuốc trên người, các nhà nghiên cứu phải tìm hiểu xem liệu nó có khả năng gây hại nghiêm trọng (còn gọi là độc tính) đối với cơ thể con người hay không. Do vậy, các nhà nghiên cứu phải tiến hành các thử nghiệm trên động vật, còn gọi là nghiên cứu tiền lâm sàng. Có hai loại nghiên cứu tiền lâm sàng là:
- Trong ống nghiệm;
- Trong cơ thể sống.
Thông thường, mỗi quốc gia đều có một cơ quan có thẩm quyền để giám sát, thẩm định và phê duyệt về quy trình và các kết quả nghiên cứu thuốc mới. Đối với Mỹ, Cục quản lý Thực phẩm và Dược phẩm (FDA) là cơ quan thực hiện chức năng này. FDA đưa ra yêu cầu các nhà nghiên cứu áp dụng tiêu chuẩn Thực hành Phòng thí nghiệm Tốt (GLP). Tiêu chuẩn này là yêu cầu bắt buộc trong các quy định phát triển sản phẩm y tế, cho các nghiên cứu tiền lâm sàng. Các quy định này đặt ra các yêu cầu (tiêu chuẩn) cơ bản đối với:
- Tiến trình nghiên cứu;
- Nhân viên nghiên cứu;
- Cơ sở nghiên cứu;
- Thiết bị sử dụng trong nghiên cứu;
- Quy trình nghiên cứu;
- Quy trình vận hành;
- Báo cáo nghiên cứu;
- Một hệ thống giám sát đảm bảo chất lượng cho mỗi nghiên cứu để giúp đảm bảo tính an toàn của sản phẩm do FDA quản lý.
Các nghiên cứu tiền lâm sàng thường không quá lớn. Tuy nhiên, những nghiên cứu này phải cung cấp thông tin chi tiết về liều lượng và mức độ độc tính của các thuốc mới. Sau khi thử nghiệm tiền lâm sàng, các nhà nghiên cứu sẽ xem xét lại kết quả và quyết định xem có nên tiếp tục tiến hành thử nghiệm thuốc trên người hay không (nghiên cứu lâm sàng) (còn tiếp).

